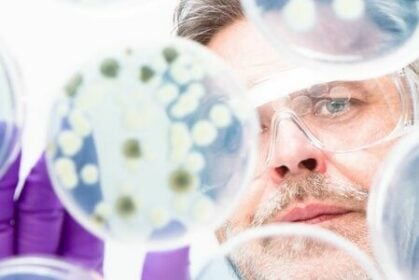
csm_csm_Image1_8fabd10baa_9408c5c31f

Pourquoi l’antibiorésistance est-elle si grave ?
L’antibiorésistance est un problème grave de santé publique, elle progresse extrêmement rapidement partout dans le monde depuis les années 2000. En 2015, l’Organisation Mondiale de la Santé (OMS) tirait le signal d’alarme face à l’utilisation abusive et excessive des antimicrobiens dans la médecine humaine et la production alimentaire, conduisant à une multirésistance bactérienne.
« Si nous n’agissons pas immédiatement et de façon coordonnée à l’échelle mondiale, nous nous dirigerons vers une ère post-antibiotique où des infections courantes pourraient être à nouveau meurtrières. » Dr Margaret CHAN, directrice générale de l’OMS.
La résistance bactérienne aux antibiotiques pourrait ainsi devenir l’une des principales causes de mortalité dans le monde d’ici à 2050.
Limiter l’antibiorésistance requiert donc une prévention active axée sur le bon usage des antibiotiques, l’hygiène des mains et la prévention des infections. Dans ce cadre, le prescripteur, le laboratoire de biologie médicale et les patients ont un rôle essentiel à jouer.

 Dépistage des infections sexuellement transmissibles au labo, sans ordo et sans frais, pour tous
Dépistage des infections sexuellement transmissibles au labo, sans ordo et sans frais, pour tous